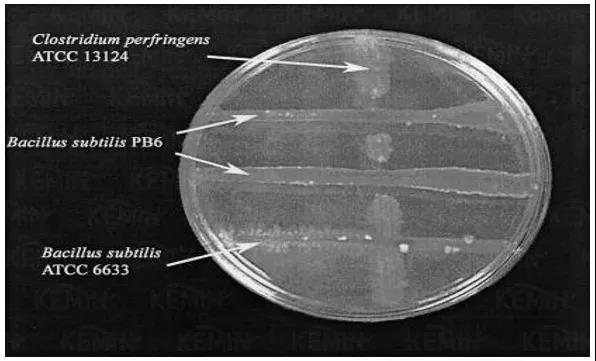

您的留言已提交,谢谢!
5秒后将自动关闭


年初替代谷物原料的大量使用,当时就担忧饲料内非淀粉多糖(NSP)含量的增加可能会引起更多的肠道健康问题。
果不其然相比去年下半年,今年以来,发现鸡猪的腹泻率真的增加啦!
—文 | 聂康康
建明(中国)科技有限公司
让我们来看看是哪些因素引起的该现象?
其实,引起畜禽腹泻的因素极为复杂,主要有传染性因素、营养性因素和饲养管理因素。
但是走访市场发现引起今年畜禽腹泻率增加主要有3个方面因素,除了上面所说的替代谷物原料以外,还有添加剂使用问题和生物安全问题。
-01- 饲料原料问题
替代谷物原料的大量使用导致食糜粘度增加,增加肠道炎症风险
今年玉米价格持续高位,小麦、大麦、糙米等替代谷物原料在饲料配方中大比例使用。
相比玉米来说,小麦等替代谷物原料中非淀粉多糖含量要比玉米高得多(见表1)。
表1 小麦和玉米中非淀粉多糖的含量(建明CLS,2020)

导致肠道内食糜粘度增加,为肠道后端的产气荚膜梭菌等有害菌提供有利生长环境,导致肠道炎症,从而出现腹泻现象。
主要替代物小麦内呕吐毒素含量普遍严重超标,易诱发坏死性肠炎
更可怕的是,经建明CLS检测,发现很多玉米、小麦等饲料原料内霉菌毒素含量严重超标,尤其是小麦内呕吐毒素含量普遍严重超标,严重影响肠道上皮细胞的完整性(见图1),造成肠道炎症,也易诱发坏死性肠炎的发生。

-02- 添加剂使用问题
以牺牲功能性添加剂来降低饲料成本,导致肠道问题增加
今年以来多畜种价格持续低迷,进入长时间深度亏损。
因此,很多企业为了优化饲料成本,减少亏损,使用的原料更杂、营养浓度更低、功能性添加剂更少,或在选择功能性添加剂方面,尤其针对改善肠道健康的添加剂,过度看重处理成本,而忽略了产品本身的功能性。
比如在益生菌的选择和使用,市场上益生菌类产品参差不齐,其功能性更加差异巨大,如何评估益生菌的效果就至关重要。
综合评估才能筛选出优秀的益生菌产品,才能确保益生菌在肠道发挥稳定高效的作用
益生菌作为当下饲料替抗的核心产品之一,应进行综合的评估。
首先要评估益生菌的杀菌效果(见图2)。
图2克洛生®(枯草芽孢杆菌PB6)和其他枯草芽孢杆菌对产气荚膜梭菌抑制效果比较(Patent No.: US 7,247,299 B2; 2007)
图2克洛生®(枯草芽孢杆菌PB6)和其他枯草芽孢杆菌对产气荚膜梭菌抑制效果比较(Patent No.: US 7,247,299 B2; 2007)
要通过实验室体外和动物体内的测试,明确对比不同益生菌对致病菌的抑制能力。
其次,益生菌必需具备稳定的环境抗逆性表现,比如饲料生产中的高温制粒、畜禽体内胃酸、胆碱等理化条件对益生菌的影响。
同时也要评估与其他抗球虫药、酸化剂及其它添加剂的兼容性情况。
从而确保益生菌在动物体内发挥稳定高效的效果。
-03- 生物安全问题
生物安全的放松也是导致腹泻的一个核心因素
当下养殖端多畜种的持续亏损,尤其是黄鸡和毛猪,已经进入深度亏损。
导致终端养殖场为了节约成本,进行大量裁员,减少添加剂和疫苗用量,放松生物安全管理,导致畜禽更加容易引起腹泻。
众所周知,只有在动物健康的情况下,才能使造肉成本最优化。
身处替代谷物原料大量应用时代,建议大家选择优秀的改善肠道健康的添加剂、做好原料品控,优化农场现场管理及生物安全等措施,才能比较有效地控制猪鸡腹泻。